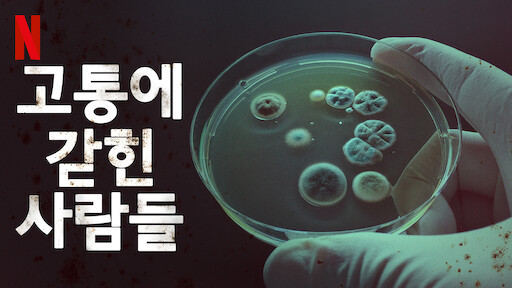
고통에 갇힌 사람들.jpg

정신병 그 애매함의 극치 ‘신의 구부러진 선'
인간의 정신에 관심이 많은 저는 과연 인간의 정신병이 완치가 되는 건지 의심스러울 때가 많습니다. 스페인의 히치콕이자 프로이트의 후예 오리올 파울로 감독의 신작 ‘신의 구부러진 선(’os Renglones Torcidos de Dios)을 보면서 제 느낌이 맞다는 생각을 했습니다. 넷플릭스에는 제 생각을 확신으로 굳혀 준 또 하나의 다큐가 있는데요, 바로 2018년에 넷플릭스가 제작한 ‘고통에 갇힌 사람들’입니다 모두 7부작으로 CT MRI 초음파 혈액검사 소변검사 모두 정상이지만 도저히 병명을 모르고 극도의 고통 속에 살고 있는 수많은 사람들의 이야기입니다. 즉 사지는 멀쩡한데 뇌는 끝없는 고통을 호소하는 거지요. 별의별 고통이 다 있습니다. 전자파 때문에 스마트폰만 보고도 소름이 돋는 사람, 집에 언제든 생기는 곰팡이 때문에 집을 떠나 1년째 길 위에서 자동차로 이동하는 사람, 12명의 의사를 만났는데 12명의 이사가 모든 다른 진단을 내린 환자 등 현대의학은 정신의 고통을 다루는 데 속수무책입니다. 병원에서 환자들이 자신의 병을 이야기하면 병원 관계자들도 그게 무슨 병이냐고 묻습니다. 근육긴장이상증, 만성피로증후군, 또 어떤 병은 잠이 들만 하면 아드레날린이 솟구치는 질병도 있습니다. 각성된 상태로는 잠을 잘 수 없으니 죽을 노릇이죠. 정신과 의사들은 심지어 당신 안 아픈데 당신 상상이 병을 만든 것 아니냐는 식으로 따지는 경우도 있다고 합니다. 정신과 의사가 사람의 몸을 들여다볼 수는 있어도 사람의 말과 행동 외에 사람의 정신을 들여다볼 방법이 없기 때문입니다.
1) 2시간 29분 동안 완벽했던 플롯 1분의 마무리로 뒤집히다
영화는 사립 탐정이 정신병원에 위장 환자로 잠입해 그 안에서 벌어진 살인사건의 진실을 밝히는 과정입니다. 그런데 영화에는 또 하나의 시선이 있습니다. 바로 병원 원장이죠. 그는 이 사립탐정을 망상 장애 환자로 취급합니다. 관객은 둘 중에 누가 잔실을 말하는지 찾는 심리게임이죠. 영화는 처음부터 여주인공 편이었습니다. 그녀의 말의 신뢰성을 확인해가는 정신과 의사들은 결국 그녀를 정신병 환자가 아니라고 판단하고 그녀를 퇴소시킵니다. 여기서 끝났으면 관객도 해피해졌을 겁니다. 여주인공은 정신병자가 아니고 함정에 걸려든 불쌍한 여인이며 그녀를 궁지에 몬 사람이 원장이라는 특유의 선악 구조를 이 영화도 갖추었다고 봐야죠. 그러데 결말 1분이 이 모든 것을 바꿉니다. 여주인공이 자신에게 자신의 아들이 자살인지 아닌지를 증명해달라고 부탁했던 그 사람이 나타나 그녀에게 말을 건네는 순간 영화는 끝납니다. 갑자기 무대에서 배우들이 커튼콜을 하는 도중 커튼이 내려가는 느낌을 받게 되죠. 영화가 더 이어지면서 반전을 섬세하게 보여줄 것은 관객들은 기대했을 깁니다. 상당한 실력파인 감독이 그럴 능력이 없어서일끼요? 아니라고 생각합니다. 의도적인 끊기입니다. 바로 인간의 정신을 다른 인간이 알 수 없다는 애매모호함을 말해주기 위해서 급작스럽게 영화를 끝낸 겁니다.
2) 정신과 의사도 모르는 인간의 정신병
조현병 트라우마 우울증 불면증 불안장애 공황장애 셀 수 없이 많은 정신 질환 중에 여러분 완치되었다는 이야기를 들으신 분이 계신가요? 우울증으로 고생했는데 지금은 해피해!, 불명증으로 고생해 수면제를 매일 먹었는데 오늘부터 수면제 끊고 잠을 축 자게 됐어! 이런 이야기를 저는 들은 적이 없습니다. 조현병을 제외한 나머지 정신 질환은 대부분 호르몬 약을 먹고 일상생활을 영위해나갑니다. 조현병 치료를 위해서는 전두엽에 여전히 손을 대고 영화에서처럼 인슐린 요법을 쓰는 경우도 아직도 있습니다. 놀랍게도 정신병은 완치되는 병이 아닙니다. 평생 약을 먹거나 극단적인 선택(우울증 환자의 15%)을 하거나 둘 중에 하나라고 해도 과언이 아닐 정도로 현대 의학은 정신 의학에서 무력합니다.
영화 관객이 끝까지 보고도 그녀가 정신병자인지 함정에 빠진 불쌍한 여자인지를 끝내 몰랐던 것처럼 신경정신과 의사들은 환자를 보고도 그 환자가 진짜 무엇 때문에 고통스러워하는지 어떻게 해야 고통을 끊을 수 있는지 모르는 건 아닐까요? 환자에게 몇 마디 물어보고 그림 테스트를 해본 뒤 환자가 무슨 무슨 병을 앓고 있다는 진단을 내리는 게 인간의 병든 정신에 대한 올바른 대우일까요? 영화의 압권은 환자를 퇴소시키기 위해 그를 만난 정신과 의사들이 만장일치로 환자의 상태를 결정하는 대목입니다. 만장일치로 퇴소가 결정된 것처럼 보이지민 그들 중에 어느 누구도 확신하는 분위기는 아니었습니다. 해고되어 투표 자격을 잃은 원장이 확신하는 유일한 인물처럼 보이지만 그도 퇴장하면서 영화는 생략으로 끝났습니다. 독자가 알아서 상상하라는 거죠. 저는 이렇게 영화를 보고 상상을 이어나가는 영화들이 좋습니다. 이게 현대 의학 특히 정신 의학의 한계가 아닐까요? ‘신의 구부러진 선’은 전지전능한 신이라면 만들어낼 일이 없는 정신병자를 가리킨다고 원장이 말을 했는데요, 신이 전지전능하다면 왜 구부러진 선을 만들겠습니까? 그것도 참 이상한 일이죠.
제가 생각할 때 인간이 겪는 신경 질환은 원인이 스트레스입니다. 극심한 스트레스가 있는데 오히려 정상적으로 살아가는 게 이상한 일이죠. 인간이 처한 스트레스 상황을 회피하지 않고 정면 승부하려 하지 않는 한 누구나 앞에 말한 신경 질환을 겪을 수 있습니다. 사실 몸과 마음은 연결되어 있기에 마음이 아프면 몸도 아프고 몸이 아프면 마음도 아프죠. 결국은 제가 생각할 때 가장 좋은 정신병의 치료는 전체론적 접근뿐입니다. 사람의 정신과 몸이 합일체라는 생각을 하면서 치료와 치유를 병행하는 길만이 답이죠.
신경정신과의 가장 큰 문제는 환자를 묶으려고 한다는 사실이죠. 저마다 다른 환자들이고 저마다 다른 이유에서 정신적 고통을 느끼는 사람들인데 현재 의사들은 자신이 배운 환자의 유향으로 분류하려는 경향이 강합니다. 뇌과학이 발달하고 fMRI 기술이 발달하면서 인간의 뇌에 대한 이해는 늘었지만 인간이 정신적으로 겪는 고통을 뇌가 보여주는 데는 한계가 있습니다. 그러니 미국에는 자신만의 고통에 갇힌 사람들이 그렇게 많은 것이죠.
인간의 정신은 0과 1의 컴퓨터가 아니라 그 사이에 수많은 점들로 연결된 전형적인 아날로그입니다. 다만 그 사람의 행동이나 말은 그 사람의 수많은 생각 중에 표면화된 극히 일부의 모습이기 때문에 사람이 디지털적으로 행동하고 선택하는 것처럼 보일 뿐이죠. 인간은 특히 정신적으로 극도로 애매한 존재입니다. 감독이 일관성과 논리성으로 일관하다 갑자기 턴한 이유도 인간의 애매모호성을 말하고 싶었기 때문이 아니었을까요?